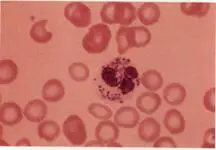
圖片描述

111年:(醫檢)血液(1)
承上題【下圖所示之白血球形態,最可能出現於下列何種疾病?】,該疾病的嗜中性球之何種功能最不受影響 ?
AAdhesion
BPhagocytosis
CBacterial killing
DChemotaxis
詳細解析
本題觀念:
本題探討先天性中性白血球功能障礙,著重Chediak–Higashi syndrome(CHS)的形態學特徵與功能缺陷。考生須將巨型嗜中性球顆粒的影像特徵與不同中性球功能(黏附、趨化、吞噬、殺菌)之受損程度對應,並據此辨別最少受影響的功能。
影像分析:
影像中可見一顆成熟中性球,其細胞質內散佈數個大而深藍灰色的顆粒,尺寸遠大於正常azurophilic granules,呈片狀或不規則圓形,遍佈整個細胞質;細胞核仍保留多葉型,但可見少量細胞質空泡。紅血球外觀正常,未見明顯變形或包含體。此種巨型顆粒源自嗜天青顆粒(azurophilic granules)與部分特異性顆粒(specific granules)異常融合,為Chediak–Higashi syndrome的典型周邊血象表現 (haematologica.org)。
選項分析
- 選項A Adhesion
CHS嗜中性球在黏附(adhesion)上並無異常,與正常細胞相同,能於血管內皮黏附並通過血管壁 ([pubmed.ncbi.nlm.nih.gov](https://pubmed.ncbi.nlm.nih.gov/4942966/?utm_s
...(解析預覽)...

升級 VIP 解鎖圖文解析